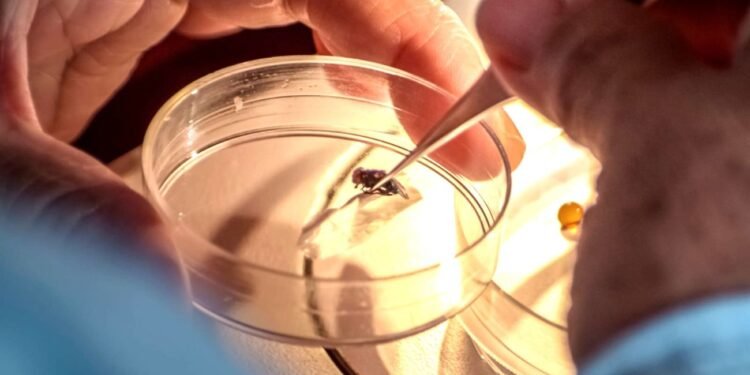
Campeche, bajo control sanitario por gusano barrenador

Por Karina Gómez
SAN FRANCISCOO DE CAMPECHE, Camp., a 9 de enero del 2026. – El estado se mantiene bajo un esquema de control sanitario y vigilancia epidemiológica permanente ante la presencia del Gusano Barrenador del Ganado (GBG), informó la Secretaría de Agricultura y Desarrollo Rural (AGRICULTURA), al reportar una reducción del 57 por ciento en los casos activos a nivel nacional.
De acuerdo con el Servicio Nacional de Sanidad, Inocuidad y Calidad Agroalimentaria (Senasica), al 7 de enero de 2026 se contabilizan 492 casos activos en el país, cifra inferior al máximo registrado el pasado 10 de diciembre de 2025, cuando se reportaron mil 145 casos.
Aunque la plaga ha sido detectada en 17 entidades federativas, el 95.7% de los casos se concentra en nueve estados, entre ellos Campeche, lo que ha permitido focalizar las acciones de contención y control sanitario de manera eficiente, principalmente en la región sur-sureste.
Diagnóstico controlado
En el caso específico de Campeche, las autoridades federales mantienen un diagnóstico de riesgo controlado, con atención directa en campo, monitoreo constante y aplicación estricta de los protocolos sanitarios. Senasica reiteró que no existe afectación a la comercialización de productos cárnicos ni riesgo para la salud pública.

El delegado de la Secretaría de Agricultura y Desarrollo Rural (SADER) en Campeche, Carlos Emilio Baqueiro Cáceres, precisó que el consumo de carne es completamente seguro, ya que el gusano barrenador afecta únicamente a animales vivos de sangre caliente y no se transmite a las personas ni a los alimentos de origen animal.
Como parte de los avances nacionales, Jalisco, Morelos, Nuevo León y Querétaro ya se encuentran libres de la plaga, mientras que otras entidades reportan menos de 10 casos activos, en proceso de erradicación total.
Senasica destacó que las acciones de prevención incluyen restricciones en la movilización de ganado, inspecciones reforzadas y la liberación de moscas estériles, además de la próxima entrada en operación de una nueva planta en Chiapas que producirá dichas moscas estériles durante el primer semestre de 2026, estrategia clave para contener y erradicar el gusano barrenador en el país.